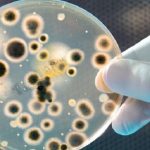
Antibiotico contro l'Acinetobacter baumannii scoperto grazie all'intelligenza artificiale

Il 68enne Vito Lorusso, primario di Oncologia medica al Giovanni Paolo II, è stato messo agli arresti per peculato e concussione subito dopo aver intascato una mazzetta di 200 euro da un malato di tumore per una visita che avrebbe dovuto garantire gratuitamente. Secondo l’accusa, era solito chiedere denaro in cambio della promessa di saltare “le rotture della coda”.

“Ti evito le rotture di palle della coda”. A parlare è Vito Lorusso, 68 anni, primario di Oncologia medica all’Istituto Oncologico Giovanni Paolo II di Bari. Ha appena terminato una visita di controllo a un paziente malato di tumore. Poco dopo viene arrestato in flagranza dagli agenti di polizia, ai quali consegna, prima ancora di essere perquisito, i 200 euro che il paziente gli ha consegnato per una visita di controllo che invece doveva essere gratuita.
Il passaggio di denaro è stato ripreso dalle telecamere installate nel suo studio dagli inquirenti, che hanno documentato sistematiche e quotidiane condotte di peculato e concussione a opera del primario. “Una spregevole consuetudine, scevra da etica professionale”, come è scritto nel verbale di arresto da parte della Procura, che evidenzia anche la “sudditanza psicologica” del paziente.
L’inchiesta è partita lo scorso 20 giugno dalla denuncia presentata da un parente di un paziente oncologico, nel frattempo deceduto. Secondo l’accusa, il primario ha sistematicamente percepito somme che non gli spettavano, garantendo ai pazienti che erano in buone mani e che li avrebbe agevolati nelle prenotazioni e nell’iter farmacologico, facendo saltare loro le fastidiose code in cambio di denaro, talvolta sottratto a persone nono solo malate, ma anche in condizioni economiche precarie.
Le intercettazioni disposte dagli inquirenti hanno catturato anche i commenti del primario, che nel corso delle visite avrebbe anche denigrato il servizio sanitario pubblico, usando frasi come “Hanno combinato un casino quelli che ti hanno operato” e “Non funziona niente, non serve a niente”. Il tutto per convincere i pazienti che, rivolgendosi direttamente a lui (a pagamento), avrebbero accorciato i tempi delle liste d’attesa. Ora Lorusso, che al momento dell’arresto non risultava ufficialmente al lavoro in ospedale, è stato sospeso dal servizio.
Redazione Nurse Times
Seguici su:
- Telegram – https://t.me/NurseTimes_Channel
- Telegram Gruppo – https://t.me/NurseTimes_Community
- Instagram https://www.instagram.com/nursetimes.it/
- Facebook – https://www.facebook.com/NurseTimes. NT
- Twitter – https://twitter.com/NurseTimes

Lascia un commento